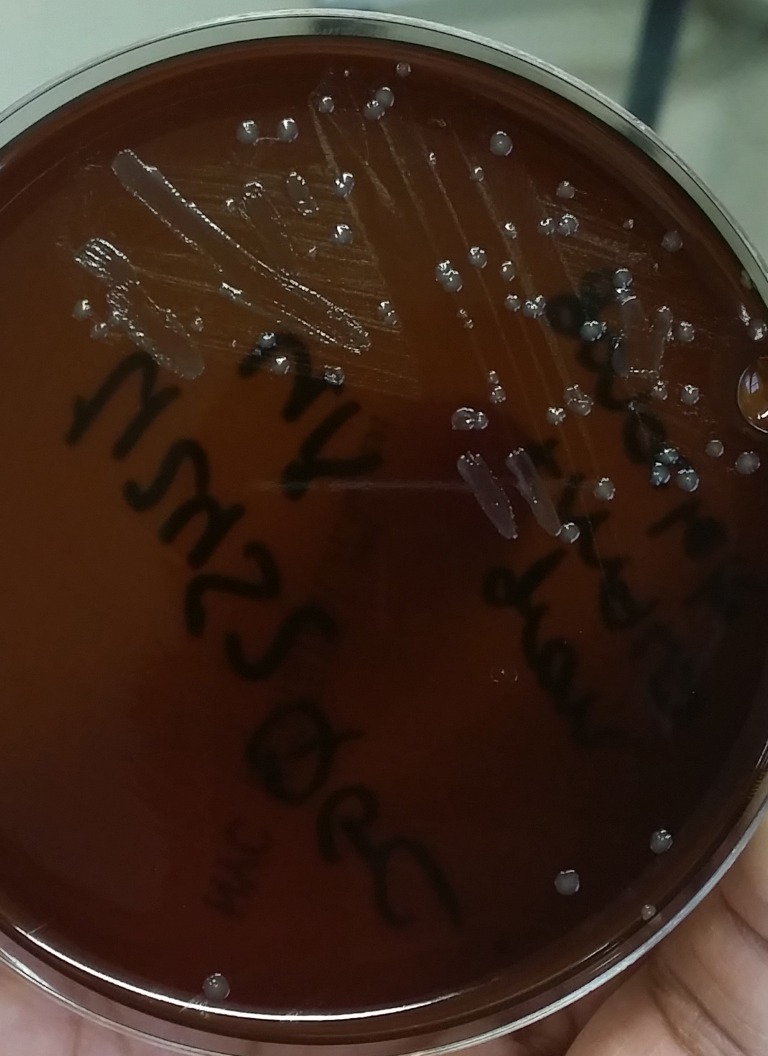

Canna-Curate Magazine VOL 2


@derangedvisions,@dynamicgreentk,@dynamicrypto, @ELAmental, @ericwilson, @fatkat, @foodforestbot, @fracasgrimm, @ganjafarmer, @goldendawne, @hotsauceislethal, @jonyoudyer, @k0wsk1 ,@krazypoet, @lyndsaybowes, @mandyfroelich,@marksheppard, @movingman,@msp-creativebot, @netgodbeerus, @olafurthor, @pataty69, @pharesim @rakkasan84, @rawpride, @realkiki85, @RebeccaRyan, @reverendrum, @SammoSK, @sgt-dan,@skylinebuds, @soundwavesphoton, @underGRound, @sapphic
Trail Makers: @jonyoudyer, @Bluntsmasha, @conradino23, @ELAmental, @netgodbeerus, @cannabiscurator, @debo4200, @sieses, @realkiki85, @doctorspence, @darkprince66, @cannaqueen, @hiatus, @tilestar, @naturalfox, @canna-collective, @deary, @foodforestbot, @nikema, @RebeccaRyanhelps, @knarly327, @Tafgongthe1st, @loryluvszombies, @spicedlife, @gjones15, @mrunderstood, @benzeta, @stoned2thebone, @cannafarms, @thegreenhouse, @cultivar, @liquid-mike, @Zainenn, @brockmorris, @ganjagirl, @MadPotters, @chey, @growingassets, @the-haze, @skylinebuds, @gingy710, @growroom, @kootsmedtree, @cowboyblazerfan. @suheri, @imammudarifqi, @grow-pro, @winnerchris, @twirlspin, @pdxlove, @cannabis-news, @cannuration, @steem420, @socialmisfit, @heyimsnuffles, @ambiguity , @phoenixwren, @batman0916, @greenfooteCO, @ceattlestretch, @njweedman, @superwoman916, @movement19, @bengiles, @growroom, @elderson, @hemp-lord, @deadisdead, @coffeebuds, @gregorypatrick, @asonintrigue, @freedomtribe, @alchemage, @stonermedal,@bembelmaniac, @mango-juice, @powpow420, @oh-high-mark, @stonerfeed, @kaz2305
A huge shout out to @a1-shroom-spores for coming up with this idea. Anybody want's to run an ad in our magazine please contact @jonyoudyer, or @bluntsmasha in the Canna-Curate Discord.
![]() | ![]() |
|---|

I dig it :-D
The community is growing so fast it is hard to keep up man.
Keep growing Canna Curate!!!
WOOT WOOT. Grow CANNA CURATE, #GHRO!
This post has been found valuable and upvoted by El surtidor
Great work and superb progress wish I had somewhere to post tshirts too! They are ink caps in the picture right? Are theses called also agar? I saw my first ones ever just 2 weeks back in the wild!
Congrats on volume #2. That #steemog is looking amazing. Also enjoyed the mushroom segment. Definitely looking forward to the next edition. More photos please!
Cheers!
@massmedicinals
Awesome my dude. I cannot wait until the season is finally over so I can have time to grow my Steem OG. I plan to by spring at the latest.